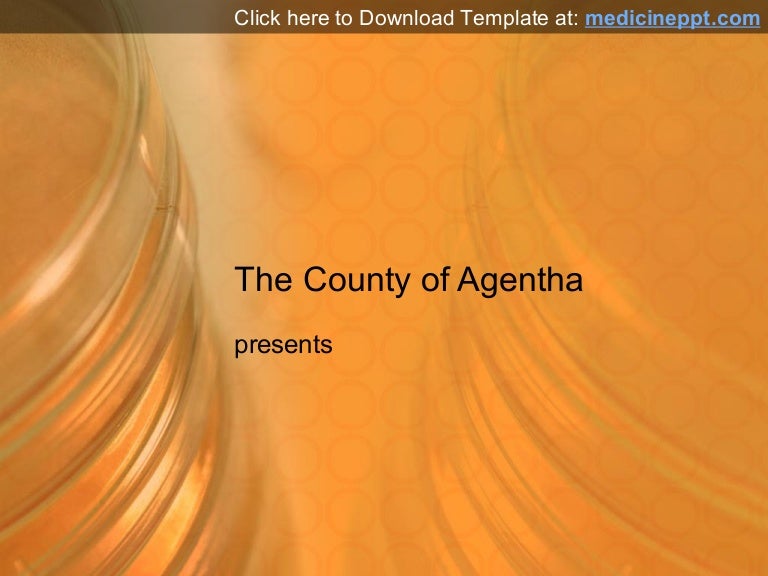
Petri Dish PowerPoint Presentation Template

If you are looking for Sustainable Energy for All Design Scenario: Inspiring design students… you've visit to the right place. We have 9 Pictures about Sustainable Energy for All Design Scenario: Inspiring design students… like Petri Dish PowerPoint Presentation Template, Petri Dish PowerPoint Background and also Aplastic anemia – Dentowesome. Here you go:
Sustainable Energy For All Design Scenario: Inspiring Design Students…
 www.slideshare.net
www.slideshare.net Cholera Public Health
 www.slideshare.net
www.slideshare.net Bacteria… A Huge World | Biology & Geology 4 ESO (2011-12)
 bio4esobil2011.wordpress.com
bio4esobil2011.wordpress.com bacteria petri
Aplastic Anemia – Dentowesome
 dentowesome.wordpress.com
dentowesome.wordpress.com aplastic anemia manifestations dentowesome
Bacterial Animation And Management
 www.slideshare.net
www.slideshare.net aureus bacterial
Petri Dish PowerPoint Presentation Template
 www.slideshare.net
www.slideshare.net petri
피부과
 www.slideshare.net
www.slideshare.net Petri Dish PowerPoint Presentation Template
www.slideshare.net
www.slideshare.net Petri Dish PowerPoint Background
 www.slideshare.net
www.slideshare.net petri
Sustainable energy for all design scenario: inspiring design students…. Bacteria petri. Petri dish powerpoint presentation template